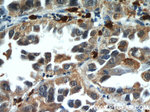
WDR18 Antibody in Immunohistochemistry (Paraffin) (IHC (P))
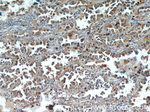
WDR18 Antibody in Immunohistochemistry (Paraffin) (IHC (P))

Search
Proteintech
WDR18 Polyclonal Antibody
{{$productOrderCtrl.translations['antibody.pdp.commerceCard.promotion.promotions']}}
{{$productOrderCtrl.translations['antibody.pdp.commerceCard.promotion.viewpromo']}}
{{$productOrderCtrl.translations['antibody.pdp.commerceCard.promotion.promocode']}}: {{promo.promoCode}} {{promo.promoTitle}} {{promo.promoDescription}}. {{$productOrderCtrl.translations['antibody.pdp.commerceCard.promotion.learnmore']}}
产品信息
15165-1-AP
种属反应
已发表种属
宿主/亚型
分类
类型
抗原
偶联物
形式
浓度
规格
纯化类型
保存液
内含物
保存条件
运输条件
产品详细信息
Immunogen sequence: MAAPMEVAV CTDSAAPMWS CIVWELHSGA NLLTYRGGQA GPRGLALLNG EYLLAAQLGK NYISAWELQR KDQLQQKIMC PGPVTCLTAS PNGLYVLAGV AESIHLWEVS TGNLLVILSR HYQDVSCLQF TGDSSHFISG GKDCLVLVWS LCSVLQADPS RIPAPRHVWS HHTLPITDLH CGFGGPLARV ATSSLDQTVK LWEVSSGELL LSVLFDVSIM AVTMDLAEHH MFCGGSEGSI FQVDLFTWPG QRERSFHPEQ DAGKVFKGHR NQVTCLSVST DGSVLLSGSH DETVRLWDVQ SKQCIRT (1-306 aa encoded by BC001648)
靶标信息
WD repeat domain 18 (WDR18) is a member of the WD repeat protein family, which is involved in a variety of cellular processes, including cell cycle progression, signal transduction, apoptosis, and gene regulation. WD repeats are minimally conserved regions of approximately 40 amino acids that commonly form a tertiary propeller structure. WDR18 is a 432 amino acid protein that contains six WD repeats and is encoded by a gene located on human chromosome 19. WDR18 may play a role during development. The complex PELP1-TEX10-WDR18 is required for the maturation and nucleolar release of the large ribosomal subunit.
仅用于科研。不用于诊断过程。未经明确授权不得转售。
生物信息学
蛋白别名: Involved in Processing ITS2 3 homolog; WD repeat-containing protein 18
基因别名: Ipi3; R32184_1; WDR18
UniProt ID: (Human) Q9BV38
Entrez Gene ID: (Human) 57418